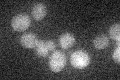
YNL309W
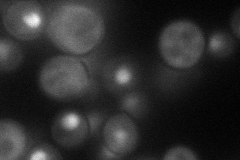
YNL309W
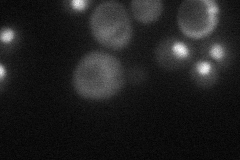
YNL309W
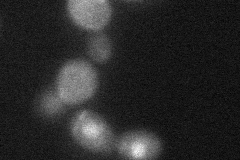
YNL309W

View description
Protein with a role in regulation of MBF-specific transcription at Start, phosphorylated by Cln-Cdc28p kinases in vitro; unphosphorylated form binds Swi6p and binding is required for Stb1p function; expression is cell-cycle regulated
Localization:
Intensity:
Fold change:
Significance:
-
C’ GFP library in SD
below threshold14.93 -
N' NOP1pr-GFP in SD
nucleus62.4816 -
N' TEF2pr-mCherry in SD
nucleus30.4318 -
N' NATIVEpr-GFP in SD

nucleus31.2862 -
N' TEF2pr-VC and Cyto-VN in SD
nucleus35.3357 -
C’ GFP library in SD+DTT

cytosol16.441.1No -
C’ GFP library in SD+H2O2

cytosol14.961No -
C’ GFP library in Starvation Media

cytosol15.61.04No -
C’ GFP library on the background of Pup2-DaMP

below threshold -
C’ GFP library on the background of CCT mutant

below threshold15.73071.05331No
